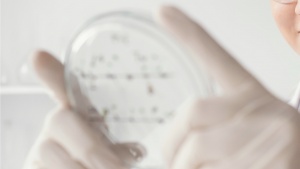
''

Senhora Presidente, Senhora Comissária Zaharieva, o progresso científico e tecnológico não pode ser espartilhado na lógica da política da competitividade em função dos objetivos de acumulação de lucro dos grandes grupos económicos e financeiros.
O progresso científico e tecnológico tem de ser encarado como um instrumento para responder a necessidades económicas e sociais, para resolver problemas que atingem a vida dos povos. Tem de ser encarado como um espaço absolutamente fundamental para o progresso e o desenvolvimento nacional e para o combate às assimetrias regionais e nacionais que existem no espaço da União Europeia. Porque, naturalmente, os países não partem todos do mesmo nível de desenvolvimento científico e tecnológico.
E é por isso que precisamos de um papel central dos Estados na criação de condições para o desenvolvimento do progresso científico e tecnológico e para a apropriação social e coletiva dos seus resultados.
É por isso que precisamos de políticas de valorização profissional e social dos investigadores e do pessoal de investigação dedicado à atividade científica, porque essas são condições absolutamente fundamentais para que a ciência e a tecnologia se desenvolvam livremente e não em função de objetivos de militarismo e de guerra.